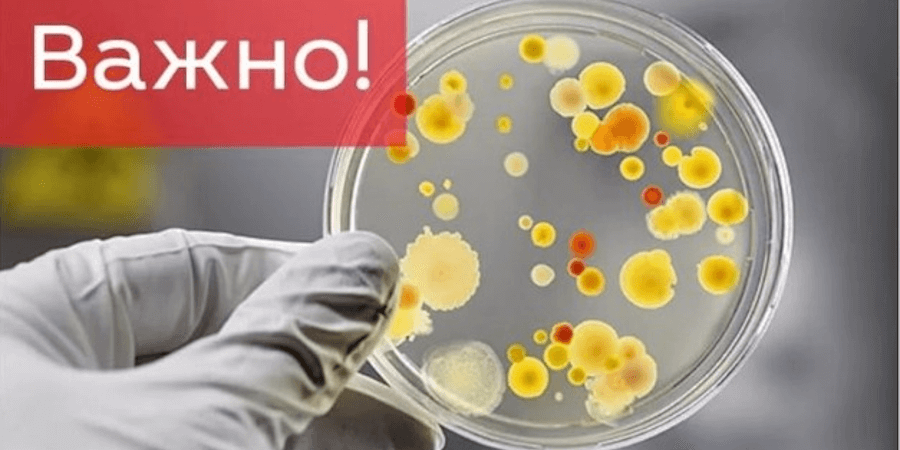

Министерство труда и социальной защиты населения РК подготовило ответы на 18 наиболее часто задаваемых гражданами вопросов касательно назначения единовременной выплаты из Государственного фонда социально страхования на случай потери дохода в связи с введением ограничительных мер в июле т.г. в размере минимальной заработной платы – 42 500 тенге.